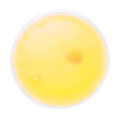
JAUNE

PACK CHAUFFANT KISON
Chaufferette transparente réutilisable avec gel coloré.
- Matériel: Plastique
- Taille: ø100×10 mm
Nous pouvons imprimer votre logo sur ce produit. Pour recevoir notre devis, cliquez sur le bouton "PERSONNALISATION".
Matériel: ABS, ABS
Code: AP781012
Prix sans TVA : 2,05 CHF
Prix avec TVA : 2,05 CHF